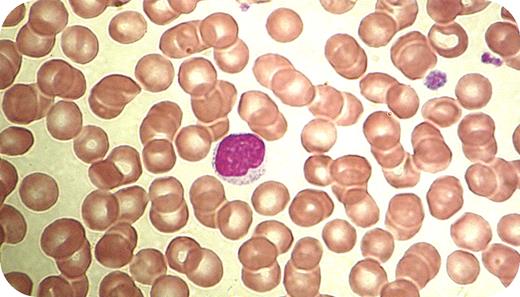
A 28-year-old woman with Hodgkin disease was about to begin her final course of chemotherapy when afternoon fevers, nausea, lethargy, and mild dyspnea developed. During previous treatments, her adenopathy and hepatomegaly resolved and chest x-rays showed a disappearance of the mediastinal mass. Along with the development of new symptoms, she had tender nodes in the neck and axilla. There were no new medications and no contact with people who were ill. Her cat had been in her house for several years. Complete blood count showed a mild anemia, normal platelets, and mild leukocytosis. The absolute lymphocyte count was 8.2 × 109/L (blood smear shown). Prior to an extensive reassessment for a presumed relapse of Hodgkin disease, laboratory tests were ordered for connective tissue diseases, thyroid disorders, viral infections including HIV, and serologic tests for toxoplasmosis. The toxoplasmosis test was IgM positive with a low titer positive IgG. When retested 2 weeks later, along with the first specimen, IgM was still positive and the IgG titers had significantly increased. Chemotherapy was held and she was placed on antibiotics. / Atypical lymphocytes can be found in viral and protozoal infections. Toxoplasmosis may develop in immunocompromised hosts, such as Hodgkin disease, as a new infection or from reactivation of latent toxoplasmosis.

A 28-year-old woman with Hodgkin disease was about to begin her final course of chemotherapy when afternoon fevers, nausea, lethargy, and mild dyspnea developed. During previous treatments, her adenopathy and hepatomegaly resolved and chest x-rays showed a disappearance of the mediastinal mass. Along with the development of new symptoms, she had tender nodes in the neck and axilla. There were no new medications and no contact with people who were ill. Her cat had been in her house for several years. Complete blood count showed a mild anemia, normal platelets, and mild leukocytosis. The absolute lymphocyte count was 8.2 × 109/L (blood smear shown). Prior to an extensive reassessment for a presumed relapse of Hodgkin disease, laboratory tests were ordered for connective tissue diseases, thyroid disorders, viral infections including HIV, and serologic tests for toxoplasmosis. The toxoplasmosis test was IgM positive with a low titer positive IgG. When retested 2 weeks later, along with the first specimen, IgM was still positive and the IgG titers had significantly increased. Chemotherapy was held and she was placed on antibiotics.
Atypical lymphocytes can be found in viral and protozoal infections. Toxoplasmosis may develop in immunocompromised hosts, such as Hodgkin disease, as a new infection or from reactivation of latent toxoplasmosis.
A 28-year-old woman with Hodgkin disease was about to begin her final course of chemotherapy when afternoon fevers, nausea, lethargy, and mild dyspnea developed. During previous treatments, her adenopathy and hepatomegaly resolved and chest x-rays showed a disappearance of the mediastinal mass. Along with the development of new symptoms, she had tender nodes in the neck and axilla. There were no new medications and no contact with people who were ill. Her cat had been in her house for several years. Complete blood count showed a mild anemia, normal platelets, and mild leukocytosis. The absolute lymphocyte count was 8.2 × 109/L (blood smear shown). Prior to an extensive reassessment for a presumed relapse of Hodgkin disease, laboratory tests were ordered for connective tissue diseases, thyroid disorders, viral infections including HIV, and serologic tests for toxoplasmosis. The toxoplasmosis test was IgM positive with a low titer positive IgG. When retested 2 weeks later, along with the first specimen, IgM was still positive and the IgG titers had significantly increased. Chemotherapy was held and she was placed on antibiotics.
Atypical lymphocytes can be found in viral and protozoal infections. Toxoplasmosis may develop in immunocompromised hosts, such as Hodgkin disease, as a new infection or from reactivation of latent toxoplasmosis.
Many Blood Work images are provided by the ASH IMAGE BANK, a reference and teaching tool that is continually updated with new atlas images and images of case studies. For more information or to contribute to the Image Bank, visit www.ashimagebank.org.

This feature is available to Subscribers Only
Sign In or Create an Account Close Modal